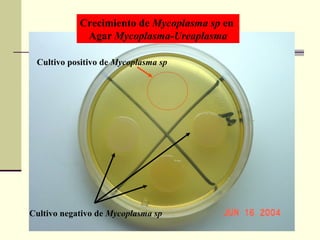
Crecimiento de Mycoplasma sp en
Agar Mycoplasma-Ureaplasma
Cultivo negativo de Mycoplasma sp
Cultivo positivo de Mycoplasma sp
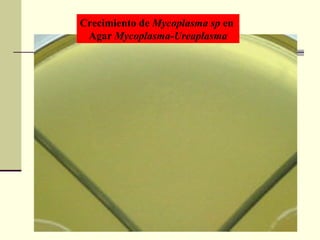
Crecimiento de Mycoplasma sp en
Agar Mycoplasma-Ureaplasma

1) El documento describe los agentes causantes comunes de neumonía, incluyendo bacterias como Streptococcus pneumoniae y Klebsiella pneumoniae, virus como la influenza, y hongos y parásitos. 2) Explica los métodos de diagnóstico para identificar estos agentes, como tinción, cultivo, y pruebas serológicas. 3) Se enfoca específicamente en Mycoplasma pneumoniae, Chlamydia pneumoniae, y Legionella, detallando sus síntomas, transmisión, tratamiento y prevención.